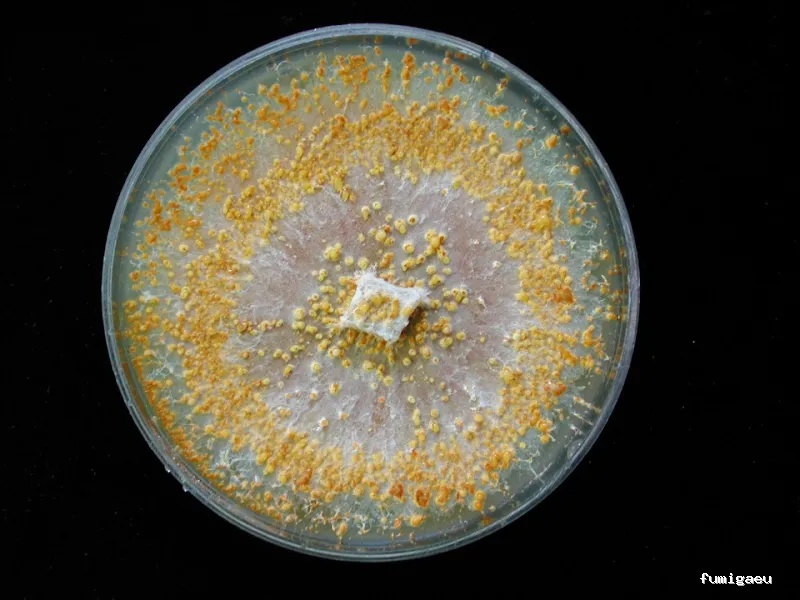
Fauna Útil

Fauna Útil
Servicio forestal • Forcadela
info Acerca de
Fauna Útil se constituyó en el año 2000 con el objetivo de desarrollar y comercializar productos biológicos para el control de plagas y enfermedades en producciones agrícolas y forestales, mediante investigaciones propias o proyectos de I+D+i en colaboración con centros de investigación y otras entidades.
location_on Carretera A Guarda-Tui, Km. 194, 36730 Forcadela, Pontevedra, España
handyman Servicios
Acceso para sillas de ruedas
Accesibilidad
Aparcamiento adaptado para sillas de ruedas
Accesibilidad
photo_library Galería de Imágenes
Resumen de las opiniones
verified Basado en reseñas reales, resumido con IA
Es destacable que algunos clientes han recomendado a Fauna Útil para controlar plagas y fumigar, lo que indica que la empresa tiene una buena reputación en este ámbito. Sin embargo, no todas las reseñas son positivas. Un cliente ha expresado su descontento con la comercialización de una especie invasora, lo que plantea una preocupación legítima sobre el impacto ambiental de los productos de la empresa. Aunque esta reseña es la única negativa, es importante que la empresa tome en consideración esta crítica y evalúe sus prácticas para asegurarse de que están siendo responsables con el medio ambiente.
En general, la experiencia de los clientes con Fauna Útil sugiere que la empresa ofrece productos y servicios de alta calidad, con un enfoque en la atención al cliente y la eficacia. Aunque hay una crítica legítima que debe ser tomada en consideración, la mayoría de los clientes han tenido una experiencia muy positiva con la empresa. Esto sugiere que Fauna Útil es una opción confiable para aquellos que buscan soluciones efectivas para controlar plagas y fumigar.
star Reseñas de Clientes
Basado en 12 reseñas
Victor Manuel Parcero Masey (VICTOR M)
Fecha de edición: Hace 8 años
Quieres fumigar o controlar una plaga, llámalos
Cecilia Brandon Dominguez
Hace 6 años
Ceci Brandon
Hace 6 años
Ricardo Pacheco
Hace 4 años
imadixital
Hace 4 años
Josemaria
Hace 4 años
Magnífica antención, indicaciones de aplicación clarísimas, envío perfecto y personal super agradable. En mi caso se trataba de un tratamiento biológico para la avispilla del castaño
Jose A Nieto Castro
Hace 4 años
Gonzalo PR
Hace 3 años
Todo muy bien
Emilio Rodríguez
Hace 3 años
🥰
Juan Antonio
Hace 2 años
Muy profesionales
rate_review Deja tu Reseña
Ubicación
Aviso importante
La información mostrada en esta ficha ha sido recopilada de fuentes públicas proporcionadas por el propio negocio. Esta ficha debe servir únicamente como toma de contacto inicial. Recomendamos realizar una investigación más exhaustiva y solicitar referencias antes de contratar cualquier servicio.